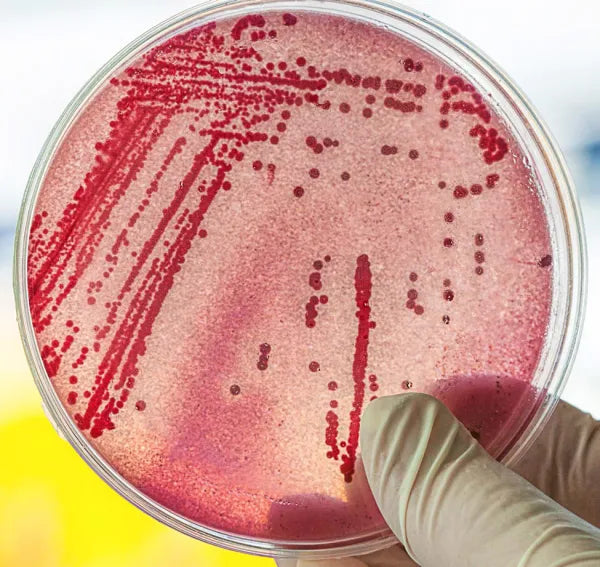
Food Safety Image

Time to read: 4 minutes
At TummyFriendly Foods, we are committed to provide the maximum possible bio-available nutrition from Real-Food with 18 nutrient-rich sprouted whole grains, pulses, vegetables, fruit and nuts.
No, I am not talking about God😂.
It’s the Microbiome! Yes, microbiomes are everywhere. They are in the air, in the water, in the food and on all the surfaces. A few of the pathogenic microbiomes like coliform, eColi, Staphylococcus aureus, Salmonella, Shigella, yeast and mold are the main reason for many types of food-borne illnesses. Studies show that 70% of the children have at least one episode of diarrhea by their first birthday.
Kids’ little tummies are immature to handle these harmful bacteria! With very low immunity levels the children under 2 years of age are categorized as “High-Risk Group” for these pathogenic bacterial infections. So Food-Safety is the utmost important factor with regard to Kids’ food.

As per BIS (Bureau of Indian Standards, the regulatory authority for Baby-Food in India), baby food should be free of these harmful bacteria.
But 90% of the food products present in the market fail in the microbial tests. How do we know? Because we tested many of these food products in our Microbial lab.
Your parI must admit that it is not an easy task to completely get rid of this invisible bacteria and viruses. We must follow very strict, daily hygiene best-practices, sterilization to completely eliminate the microbiomes. At TummyFriendly Foods, we follow the best hygiene practices and take necessary measures to completely eliminate the microbiomes from our products and the premises. We have established an in-house microbial lab as per BIS guidelines to check every batch for any microbial contamination. We conduct all the microbial tests as per BIS standards to ensure that our products are completely free of these harmful bacteria. The moisture level of the food products is maintained well below 4% to ensure that the microbiomes will not be born in the food even in the future, throughout the shelf-life of the product. agraph goes here...



After thorough research, we have designed our TummyFriendly Foods to meet the maximum possible nutritional levels from the real food. We verify the nutritional levels of various batches in our in-house Chemistry Lab to make sure we get the maximum nutritional levels consistently.
One kg organic Ragi price is around 60 rupees per KG. Did you ever wonder why 200g of sprouted Ragi powder is 199 rupees? Also organic oats is 175 rupees per KG, but 200g of Oats powder is 249 rupees. Let me explain...
Generally, most ingredients prices are very less except for a few of the premium organic ingredients like Freeze-dried Banana Powder, Spinach Powder, Green Cardamom, Beetroot powder, Almonds and Cashews etc. You can easily calculate the overall cost of the food product from the above components. We have priced our products to create value for money for the customer. We hope to rework and give the best prices as our sales volumes increase in future.
